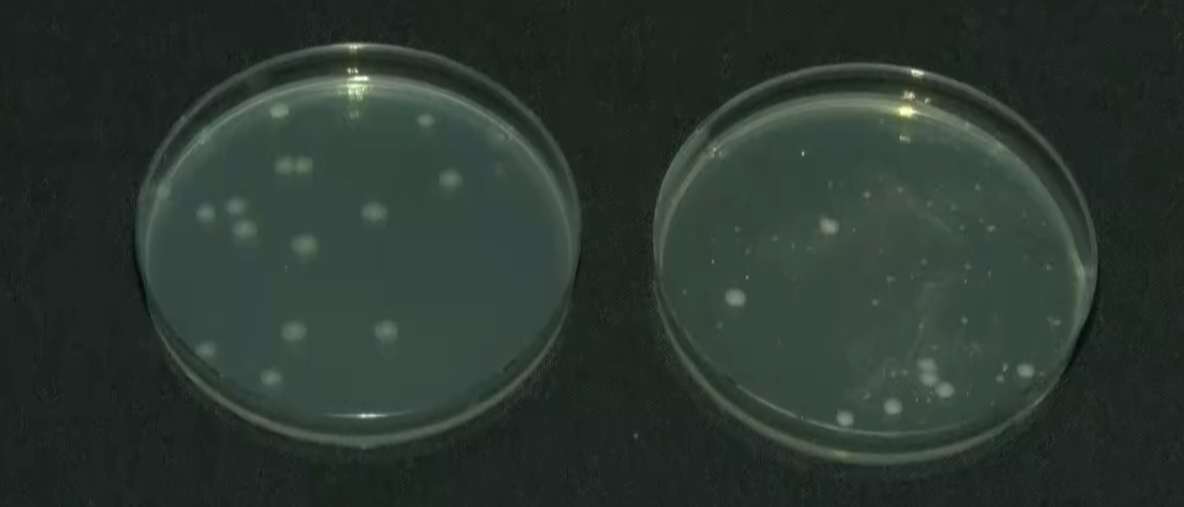

따뜻한 바람이 나오는 이유는 뭘까?
하루에 3번 습관처럼 제습기를 켠다는 주부 윤정연 씨. 이렇게 된 데에는 다 이유가 있습니다. 그 활용 가치 기대 이상이라는데요.
[윤정연 / 5년째 제습기 사용 : 땀도 덜 나고 확실히 해놓는 거랑 안 해놓는 거랑 다르기는 해요, 빨래 널었을 때는. 똑같은 26°C에서 습도가 높아지면 아무래도 조금 끈적끈적하고 더운 느낌이 있는데 제습기 틀어 놓으면 금방 뽀송해져요.]
습도가 높아 꿉꿉한 장마철에도 빨래 걱정 한 번을 안 한다는 정연 씨. 그렇다고 불편한 점이 아예 없는 건 또 아니랍니다. 낮은 습도에도 불구하고 주변 온도는 오히려 2도씩 올라가기도 한다는데. 과연 그 이유가 뭘까요? 제습기의 원리를 제대로 이해하면 그 답도 알 수 있습니다.
[최은정 / 과학교육학 박사 : 우리가 보통 사용하는 제습기는 냉각식 제습기인데요. 에어컨과 같은 원리로 냉매를 사용해서 증발기를 통과하게 되면 공기 중에 수증기가 이슬점 이하로 온도가 떨어지게 되면서 물로 응결이 되게 되는 것입니다. 이렇게 수중기가 제거된 이후에 응축기를 통과하게 되면 온도가 올라가기 때문에 뜨겁고 건조한 공기가 실내로 방출되게 됩니다.]
에어컨의 실외기는 따로 분리되어 있지만 제습기의 경우는 분리돼 있지 않아 더운 바람이 나올 수밖에 없다는 거죠.
제습기가 몸속의 수분을 빼앗아 갈까?
그런데 제습기에서 나오는 건조하고 뜨거운 바람으로 인해 몸속 수분이 빼앗긴다는 소문이 있는데요. 그래서 실험을 해보았습니다. 이 소문이 사실이라면 돼지고기 수분도 제습기 가동 후 변화가 있을 텐데요.

86.8%였던 돼지고기의 수분이 제습기의 바람에 얼마나 사라지게 될지 2시간 동안 관찰해 보았습니다. 실험결과 86.8%에서 무려 26.8%가 감소한 60%로 측정되었습니다.


그렇다면 제습기 바람이 몸속 수분을 빼앗아간다는 건 사실일까요?
[서민석 교수 / 가톨릭대학교 의과대학 가정의학과 : 문제가 될 정도로 체수분에 영향을 주지는 않습니다. 주로 체수분은 대부분 혈액이나 이런 것들로 구성이 돼 있고 아니면 세포 안에 있는 수분들도 구성 성분이 되는데, 실제로 환경에 의해서 영향을 받을 수 있는 부분은 대개 적죠. 미미해요.아무리 우리가 제습기를 쓴다고 해도 그만큼의 수분이 빠져나가지는 못하기 때문에 탈수나 이런 게 문제가 될 가능성은 없죠.]
실제 몸속 수분은 외부의 영향을 거의 받지 않는다는 거죠. 제습기에서 뿜어내는 더운 바람에 몸속 수분을 빼앗길 일은 없다고 봐도 되겠습니다.
눈의 건강에는 괜찮을까?
몸의 수분을 빼앗아 가지는 않는다고 하지만 눈도 괜찮을까요?
[송영빈 안과 전문의 : 건조한 환경이라든지 몸이 전반적으로 건조해지는 분위기라든지 그런 분위기에서는 눈의 피로도나 건조한 것들이 많이 발생하게 되죠. 실제로는 더운 건조한 바람이 더욱더 빨리 눈을 말리게 되죠. 그렇기 때문에 환경적으로는 조금 더 건조증이 심해지는 경우들도 많이 있습니다.]
눈에는 영향을 줄 수 있다는 건데요. 건조한 바람을 너무 오래 쐴 경우에는 눈물이 지나치게 증발해 안구건조증을 유발하거나 심화될 수도 있다고 하니 주의해야겠습니다.
물통에 모이는 물, 깨끗한 물일까?
제습기를 사용하다 보면 물통에 모이는 물에 대한 궁금증도 생기는데요. 이 물은 증류수처럼 깨끗한 물일까요?
[최은정 과학교육학 박사 : 제습기에 모인 물은 공기 중의 수증기가 물로 응결된 거라서 보기에는 대단히 깨끗해 보이잖아요. 하지만 제습기 자체에는 여과 장치가 포함이 되어 있지 않습니다. 그래서 정수된 물이 아니기 때문에 거기에 미생물이나 곰팡이균이 같이 딸려오는 경우가 대부분입니다. 그럴 경우에는 모여있는 물에서 굉장히 많은 다량의 미생물이나 곰팡이가 존재할 수 있습니다.]
자칫 잘못하면 물통에서 세균 번식이 활발하게 일어날 수도 있다는 것. 정말 그 안에 세균이 있는지 확인해 보기로 했습니다. 배양을 통해 확인해 본 결과는 가히 충격적이었습니다. 제습기에서 응축된 응축수를 가지고 실험한 결과 일정 부분에 미생물이나 곰팡이가 존재함을 확인할 수 있었습니다
가정집에서 사용 중인 제습기에 이렇게나 많은 곰팡이와 세균이 번식하게 된 이유가 있을까요?
[김양훈 교수 / 충북대학교 미생물학과 : 그대로 그냥 물이 모여있는 경우가 대부분이거든요. 그래서 그 안에서는 시간이 지난다거나 물통 자체가 오염이 됐다고 하면, 짧은 시간 내에 굉장히 많은 미생물이 번식할 수 있습니다.]
먼지 필터만으로 공기 중의 세균이나 곰팡이를 다 걸러내기에는 역부족인 거죠. 물통 세척이 중요한 이유입니다.
물통의 물을 화분에 주어도 괜찮을까?
그런데 물통에 모인 이 물을 화분에 준다든지 해서 재활용하는 분들도 꽤 계실 텐데요. 이게 문제를 더 키울 위험이 있다고요.
[김양훈 교수 / 충북대학교 미생물학과 : 그거를 화분 통에 붓는다고 하면 흙이 존재하고 또 흙에 영양분이 존재하게 되겠죠. 그럴 경우에는 그 흙 자체가 곰팡이로 오염이 된다든가 포자에 의해서 다른 다양한 곳에 오염이 될 수도 있습니다.]
물통 속 세균이 화분을 통해 더 많이 번식할 수 있는 거죠. 제습기에서 나온 물은 이제부터 바로바로 버리시기 바랍니다.
2~3시간 마다 환기를 해줘야
마지막으로 제습기를 사용할 때 꼭 지켜야 할 사항이 더 있다고요.
[최은정 / 과학교육학 박사 : 제습기를 틀어서 공기를 완전히 건조하게 만들었는데 창문을 열게 되면 다시 습한 공기가 들어오게 되니까 아까워서 환기를 못 하시는 경우도 있는데요. 가구나 벽지 등에서 포름알데히드와 같은 유해 물질들이 많이 방출되고 있습니다. 그리고 1층이나 지하 공간 같은 경우에는 땅이나 암석 등에서 나오는 이 라돈의 농도도 상당히 높은 편이기 때문에 계속 지속적으로 방출되면서 실내 공기를 오염시키고 있어서 반드시 환기가 필요합니다.]
제습기를 사용할 때는 2~3시간마다 환기는 필수입니다. 빠른 효과를 원한다면 공기 순환이 잘 되는 중앙부에 제습기를 배치하는 게 효과적이고요. 선풍기를 함께 사용한다면 더 빠른 효과를 기대할 수 있겠죠. 가족의 건강을 위해 일주일에 최소 1번 물통 청소 잊지 마시고요.
그런데 환기를 한다고 창문을 활짝 열어둔 채로 제습기를 사용하는 분들이 꽤 있는데요. 이럴 경우에는 실내 습도가 적정 습도까지 도달하기 어려운 건 물론이고 자칫하면 기계에 과부하까지 걸릴 수 있다고 하니까 주의하시기 바랍니다. 제습기는 문을 모두 닫은 상태에서 한두 시간만 켜두는 게 가장 효과적인 방법이라는 사실 기억하시기 바랍니다.
'항목' 카테고리의 다른 글
| 간편 송금 금지 논란 (0) | 2022.08.25 |
|---|---|
| 아기를 돌보는 할머니 할아버지, 혹은 사촌 이내 친척에게 서울시가 월 30만원을 준다고 합니다. (0) | 2022.08.25 |
| 일반 우유와 환원유의 차이점은 무엇일까요? (0) | 2022.08.22 |
| 초콜릿과 가공 초콜릿의 차이점은 무엇일까요? (2) | 2022.08.22 |
| 천연버터와 가공버터의 차이점은 무엇일까요? (0) | 2022.08.22 |
댓글